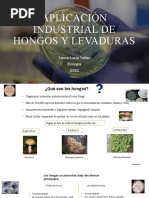

ENZIMAS EN LA INDUSTRIA TEXTIL: BIOPULIDO
Los tratamientos enzimáticos del algodón mediante enzimas denominadas celulasas, con
objeto de obtener superficies modificadas, y mejorar aspectos como la formación de pilling,
el tacto y suavidad de los tejidos así tratados, así como también su cayente
Imagen --antes del biopulido después del biopulido
Esta operación se denomina BIOPULIDO, ya que realiza un “pulido” de la superficie del
tejido, mediante la acción química de una enzima, en este caso, una CELULASA. El
tratamiento de un tejido que contiene algodón, mediante una enzima del tipo celulasa,
provoca una hidrólisis controlada de las fibras de algodón de la superficie de éste:
Imagen--. Hidrólisis enzimática de la celulosa
El biopulido, se puede realizar tanto en tejidos de calada (planos), como en tejidos de
género de punto. Los tratamientos enzimáticos, son respetuosos con el medio ambiente.
¿QUÉ SON LAS CELULASAS?
Las celulasas son enzimas que degradan las fibras celulósicas superficiales de los tejidos,
mediante un ataque específico de los enlaces 1, 4 ß gucosídicos de la molécula de celulosa,
según esquema de la página anterior.
Las enzimas del tipo celulasas, producen la hidrólisis controlada de las fibras celulósicas de
la superficie de los tejidos, dándoles u aspecto más liso y brillante. Las celulasas, también
son usadas para conseguir aspectos de envejecido, en prendas denim. Se pueden utilizar
�conjuntamente con piedra pómez, en el lavado a la piedra para obtener estos efectos de
envejecido, o simplemente sólo celulasas. Estas enzimas, tienen rangos de eficiencia
perfectamente determinados, y que vienen condicionados por el pH y temperatura de
aplicación. De forma general, se pueden clasificar las celulasas en dos grupos: 1) Celulasas
ácidas 2) Celulasas neutras Las celulasas ácidas, tienen rango de eficiencia máxima, a pH
entre 4,5 y 5,5 a temperaturas entre 45 y 55 ºC Las celulasas neutras, tuenen rangos de
eficiencia máxima, a pH entre 5,5 y 8 a temperaturas entre 50 y 60 ºC.
Imagen---. Índice de pH a lado izquierdo, temperatura °C a lado derecho.
La acción catalítica de las enzimas sobre las fibras celulósicas, además de depender de la
temperatura y en pH, se ve favorecida por la agitación mecánica asícomo por el tiempo de
tratamiento. Una vez hidrolizadas controladamente las fibras superficiales de los tejidos, y
para evitar degradaciones indeseadas de los tejidos celulósicos, se procede a desactivar la
enzima, y por tanto a detener el ataque a la celulosa. Las enzimas celulasas, se pueden
desactivar aumentando el pH a valores de 8, o también aumentando la temperatura de
tratamiento a unos 75 o 80 ºC, durante un determinado período de tiempo, que puede ser
del orden de 10 o 15 minutos. De esta forma, se impide cualquier hidrólisis posterior de la
celulosa, por parte de las enzimas. Debido a que las enzimas son proteínas naturales, son
biodegradables y por lo tanto presentan indudables beneficios desde el punto de vista
ecológico.[ CITATION Ant15 \l 9226 ]
https://issuu.com/fidel_lockuan/docs/v._la_industria_textil_y_su_control_de_calidad/12
en este habla todo el proceso del algodón y habla del antipillign también pero pues no dice
algo diferente que complemente
http://download.polympart.com/polympart/ebook/Active%20Coatings%20for%20Smart
%20Textiles.pdf
Este está en ingles entonces es tu trabajo leerlo bien ajaja porque pues creo que es
importante
�Las celulasas son proteínas naturales, que sólo reaccionan con la celulosa. Estas actúan
como catalizadores, aumentando la velocidad de la hidrólisis. Y es una alternativa a los
productos químicos utilizados para el acabado de las telas por su carácter biodegradable.
http://reaxion.utleon.edu.mx/Art_Impr_Biotecnologia_Sector_Textil.html
Me parece importante para colocarlo esta en este link
Las enzimas son las proteínas más especializadas, esto corresponde a su acción catalizadora
de los procesos biológicos: degradación de nutrientes, transformaciones energéticas,
síntesis de moléculas orgánicas, regulación de procesos metabólicos, etc.; incluso se
mantienen activas fuera de la célula. La mayoría de las reacciones celulares no se pueden
producir espontáneamente a la velocidad adecuada, pues requerirían una elevada
temperatura que sería letal para la célula, por la que es decisiva la acción enzimática para
conseguir dicha velocidad de reacción. [ CITATION Bio18 \l 9226 ] Cabe aclarar que las
enzimas en general son proteínas, pero existen otras enzimas de naturaleza
ribonucleoprotéica, denominadas ribozimas.
Las enzimas actúan sobre sustancias determinadas, conocidas como sustratos, cuya
transformación hacen posible. En muchos casos el sustrato es una sustancia muy compleja
que debe transformarse en otra u otras más simples; la enzima se une al sustrato a través de
numerosas interacciones débiles como son: puentes de hidrógeno, electrostáticos,
hidrófobos, etc., en un lugar específico, el centro activo o centro catalítico. Este centro es
una pequeña porción del enzima constituido por una serie de aminoácidos que
interaccionan específicamente con el sustrato debilitando los enlaces que mantienen unidos
a los átomos que lo forman y haciendo más sencilla su transformación. Normalmente el
�centro activo de la enzima es como una hendidura, que puede modificarse al unirse con el
sustrato.[ CITATION Bio18 \l 9226 ]
Imagen--. Unión de un sustrato con el centro activo de una enzima.